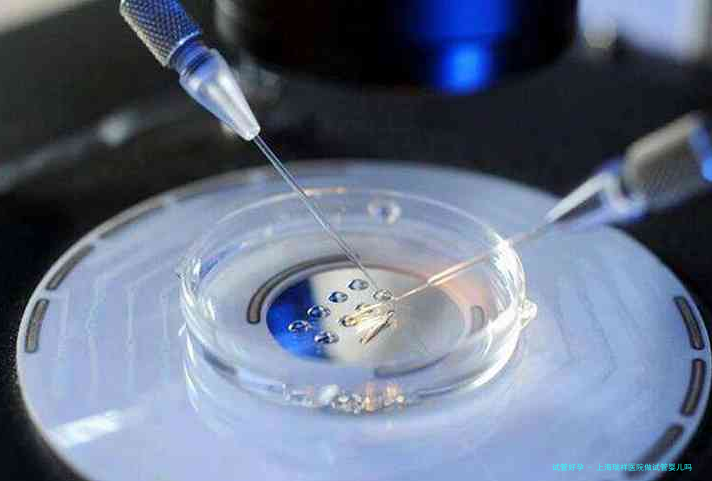

上海瑞祥医院答:上海瑞祥医院可以做试管婴儿,它是上海市一级三甲医院,坐落于上海市陆家嘴金融商业区,具有改制医学药物管理的先进管理水平和规范的医疗服务,享受“上海有名气的妇婴保健服务站点”的佳誉。
上海瑞祥医院的试管婴儿技术是南都医药学研究所和上海长椿医院联合开展的“低乙酰胆碱”(LAC)技术,采用微细控制技术,以极弱的电脉动控制备受孕卵的发育,以使它们最终便能正常受精形成正常的胚胎。瑞祥医院此项技术能够有效预防屡次尝试和严格控制,大大减少了不育症夫妻的精子品质杀伤和生殖遗传现象,根据瑞祥医院的数据,试管婴儿的出生比率达到了60%-70%。
瑞祥医院的试管婴儿技术具有优秀的安全程度和高最前线性,所以试管助孕的病患广泛选择,并且整个护理期间,医院专业的护师会给予全方位细致的护理,根据国家规则,每位病患每成功地诞生一名健康宝宝后允许再次生育,一直到患者四十五岁止。
上海瑞祥医院是上海市相较出名的专业生殖机构之一,拥有世界出众的配备和技术、富有经验的国际医疗顾问团体,为当地的独身男的女的、家庭和男的女的两方,提供各类备孕医疗和独立生殖治疗服务。
瑞祥医院的备孕医疗技术特别先进,可以提供IVF病人各种治疗和检查,以确保安全程度和成效最完美,囊括试管婴儿(IVF)检查、胚胎诊断、试管婴儿、胚胎移植以及移植预先处理等。再者瑞祥医院还提供一连串支持性治疗,如精子萃取、胚胎培养、保存胚胎储存等,以保证IVF病人在治疗过程中取得最完美结果。
上海瑞祥医院的试管婴儿技术更是当然繁衍手段的科学进步,拥有高准确、安全备孕技术, 并且现在已经实现中国首例试管婴儿成功诞生,瑞祥医院已成为试管婴儿手术治疗成功率相较高的医院之一。瑞祥医院还有本人的基因诊断室,可以正确检测病人的基因病理,易于判断治疗方案和提升试管婴儿治疗的成功率。目前上海瑞祥医院已经具有完美的器械、历史悠久的老师及久负盛名的技术,为本地病患提供最完美的试管婴儿治疗服务。

